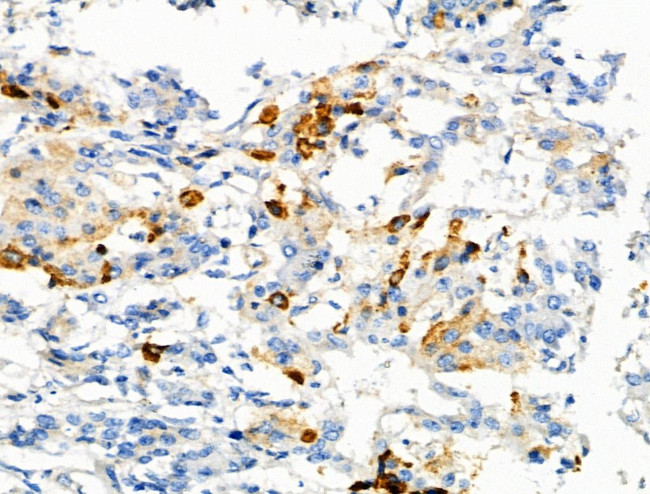
Phospho-C5AR1 (Ser327) Antibody in Immunohistochemistry (Paraffin) (IHC (P))

Search
Invitrogen
Phospho-C5AR1 (Ser327) Polyclonal Antibody
{{$productOrderCtrl.translations['antibody.pdp.commerceCard.promotion.promotions']}}
{{$productOrderCtrl.translations['antibody.pdp.commerceCard.promotion.viewpromo']}}
{{$productOrderCtrl.translations['antibody.pdp.commerceCard.promotion.promocode']}}: {{promo.promoCode}} {{promo.promoTitle}} {{promo.promoDescription}}. {{$productOrderCtrl.translations['antibody.pdp.commerceCard.promotion.learnmore']}}
图: 1 / 4
Phospho-C5AR1 (Ser327) Antibody (PA5-118773) in IHC (P)




Please note: We are reviewing Western blot images included in the antibody testing data in our catalog, including those provided by third parties. Unless expressly labeled or annotated as “raw-unedited”, Western blot images included in the antibody testing data in our catalog may have been edited, optimized or otherwise adjusted for presentation.
产品信息
PA5-118773
种属反应
宿主/亚型
分类
类型
抗原
偶联物
形式
浓度
规格
纯化类型
保存液
内含物
保存条件
运输条件
RRID
产品详细信息
Antibody detects endogenous levels of C5R1 only when phosphorylated at Ser327.
靶标信息
CD88, also known as C5aR1, is a C5a Anaphylatoxin Receptor that mediates the effects of one of the most potent chemotactic agents known. C5AR1 has been implicated in asthma, and its expression has been reported in myeloid blood cells, brain, liver, lung, spleen, heart, kidney, and intestinal tract. CD88 is the receptor for the chemotactic and inflammatory peptide anaphylatoxin C5a. Functionally, CD88 stimulates chemotaxis, granule enzyme release and superoxide anion production. CD88 is also a component of the classical pathway of the complement cascade; it may be involved with tissue injury associated with ischemia or sepsis and it may be a component of the membrane attack complex. Diseases associated with CD88 include Mannose-Binding Lectin Deficiency and Systemic Lupus Erythematosus.
仅用于科研。不用于诊断过程。未经明确授权不得转售。
篇参考文献 (0)
生物信息学
蛋白别名: C5a anaphylatoxin chemotactic receptor; C5a anaphylatoxin chemotactic receptor 1; C5a anaphylatoxin receptor; C5a ligand; C5a Receptor; C5a-R; CD88; CD88 antigen; complement component 5, receptor 1
基因别名: C5AR; C5AR1; C5R1; Cd88; D7Msu1
UniProt ID: (Mouse) P30993
Entrez Gene ID: (Mouse) 12273